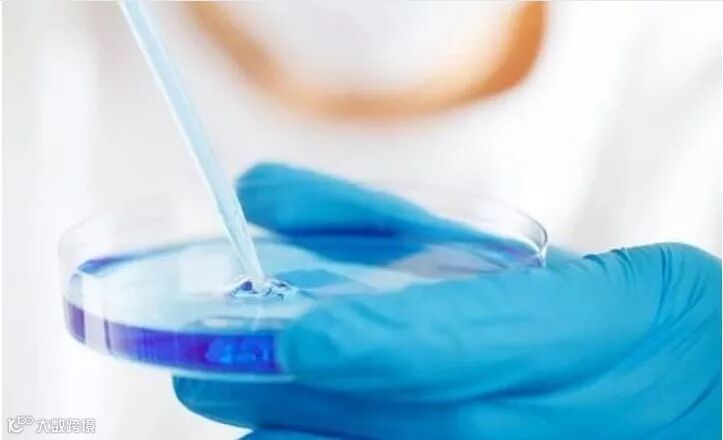

从环境来讲加拿大毋庸置疑是世界上最顶尖的国家,多伦多更是入选全世界最适宜人类居住的城市,虽然多伦多不是加拿大的首都,但却是经济中心和教育中心,世界排名前100的大学有4所都在多伦多,所以多伦多拥有了整个加拿大百分之30的人口。
从地理位置来讲,多伦多市中心驾车去往纽约也只需6-8个小时,去往底特律更是只需要4个小时。地处五大湖区,这里风景壮美,空气适宜,渔产丰富。
在多伦多这个和谐多元的城市,你看到的只是人人平等,这里有来自印度的,韩国的,日本的,南非的等等。在这个地方你不仅可以学习到全世界各自各样的文化,也可以感受到世界每个角落的美食和历史。
作为加拿大的城市,安省的省会,全球最多元化的城市之一,全球最宜居的城市之一,多伦多总是吸引着世界各地的人们。多伦多更是有两所世界级名校,不管是童鞋们选择去留学,或者移民,多伦多都成了越来越多人的首选。那么去多伦多留学生活,还有哪些绝对不能错过的事情呢?下面就跟着小编一起来看一下吧!

1.对于眩晕爱好者的盛宴
如果你觉得飞速的观光电梯不够刺激,那么你一定要去加拿大国家电视塔(CN Tower)的顶端享受一下顶级盛宴。环着瞭望台的玻璃廊道走一圈绝对可以测试出你的胆量,另外,在上面看到城市的全景图也绝对是多伦多最棒的景色。
CN Tower 是多伦多的地标,还是世界第五高的自立式建筑物。这里有116层楼高,共1776阶楼梯,每年都会举办爬楼梯比赛。这么高的建筑物还不怕找不到,在多伦多市区远远一看就能看到。
来多伦多旅游或者留学一定要带上好胃口。多伦多的人们总是很热爱食物,甚至每年都会举办美食节,一些高档餐厅也会举办一些比赛,来吸引更多的大厨和美食家。加拿大的物产丰富加上来自聚集了各国的美食家和大厨,多伦多一定会让你一饱口福,尝尽世间美食。

3.对于历史爱好者
对于历史爱好者,多伦多会有很多故事等着你去了解和探索。可以去看看古酿酒厂去看看维多利亚时代工业建筑群,还可以去看卡萨罗玛城堡里面华丽的房间,当然也不能错过热闹的圣劳伦斯市场。
来多伦多就一定不能错过多伦多动物园。在这里可以看到很多奇妙的动物,这里有哺乳动物,鸟类,冷血爬行动物等等,包括北极熊,非洲企鹅,非洲低部大猩猩,当然不能少了我们的国宝大熊猫,二顺和大毛,如果你不够了解,动物园周围都有了解一切的志愿者为你解答。

5.对于收藏达人
安大略皇家博物馆是加拿大又一地标,这里收藏着很多国家也是世界上最神秘最古老的文物。更值得一提的是,安大略皇家博物馆有除中国本土外最丰富的中国艺术品的收藏,馆内设有四个中国展厅,分别是:古代艺术、佛教艺术、建筑艺术和雕塑造像。不管是旅游还是留学,这里都是必去的地方之一。
吸引科学家到来的不仅仅是这个建筑物是雷蒙·森山的代表设计作品,更是因为这里被称为“21世纪的博物馆”。这里会向你充分展现科学的奇妙,绝对会让你大开眼界。
一年中任何时间来参观这座艺术的天堂都是好时机。这座艺术博物馆时间跨度从公元100年至今,是北美第八大艺术博物馆。同时,这座艺术博物馆还收藏了很多Henry Moore的雕塑作品,这里绝对是艺术家们不能错过的地方。
不是赛季的时候,曲棍球粉丝们往往都会去冰球名人堂,在这里可以看到最原始的曲棍球运动衫,运动员亲笔签名的海报,曲棍球历史上的大事件等。最珍贵的是你可以去 Stanley Cup 奖杯那里用任意姿势自拍留念。

加拿大多伦多大学 University of Toronto(英文缩写:U of T)作为加拿大综合排名第一,同时是加拿大建校最早的大学,是中国留学生最向往的大学之一,其历史可追溯到公元1827年的国王学院 King’s College,也就是多伦多大学的前身。由于,多伦多大学历史悠久和科研水平高,其校园和师生规模庞大,目前在大多伦多地区(Great Toronto Area, GTA)开设有包括主校区在内的三个校区。
正因为如此,很多人往往对这三个校区有着惯性的误解。常见的问题多为:“分校区是否等同于中国的‘三本’?”;“分校区的毕业证是否有别于主校区毕业证?”;“分校区的录取标准是否低于主校区”,等等很多问题,所以在选择上容易被这些所谓的“因素”误导!

多伦多大学有三个校区分别为:主校区圣乔治校区(英文缩写:UTSG)、密西沙加校区(英文缩写:UTM)、世嘉堡校区(英文缩写:UTSC)。其中主校区也被多伦多大学官方称作“市中心校区”,实际上三个校区的名称平等存在,其目的是客观性的减少人们的“惯性误解”!
U of T 多伦多大学三个校区加在一起共有700个本科专业和200个硕博专业,其中有170个本科专业在 UTM(密西沙加校区),有165个本科专业设在 UTSC(士嘉堡校区),各校区中当然有“重叠”的专业,同时,某些专业只在单独某校区开设。所以,在选择专业上,要首先选专业,次之选校区。例如,UTSC(世嘉堡校区)开设46个 Co-op 专业,在 Co-op 这方面,其他两个校区的选择就少了很多!
三个校区的录取标准上,是不存在“主校区高”“其余两个校区低”的问题,录取难度主要取决于申请人数的多少,从而造成不同专业不同年份,都有高低不一的所谓“分数线”。
所谓教育资源的不均,不过就是个伪命题!三个校区的学生在选课上都是可以互通的,例如:主校区的学生可以选UTM(密西沙加校区)的课程,这一权利也是双向的,分校区的学生也可以选择主校区的课程。学生可以自己前往所选校区上课,同时各校区之间有固定班次的校车,为往来各校区上课的学生服务。
图书馆的学习、自习或小组学习环境,无论UTSG(主校区)的图书馆或是UTM(密西沙加校区)的图书馆的资源是完全充足的。对于书籍和资料的借阅,图书馆之间是互通的,借阅和归还书籍资料是可以跨校区的。对于专业性资源,要针对自己所选专业,再来比较。



天津冠桥移民

天津冠桥海外



